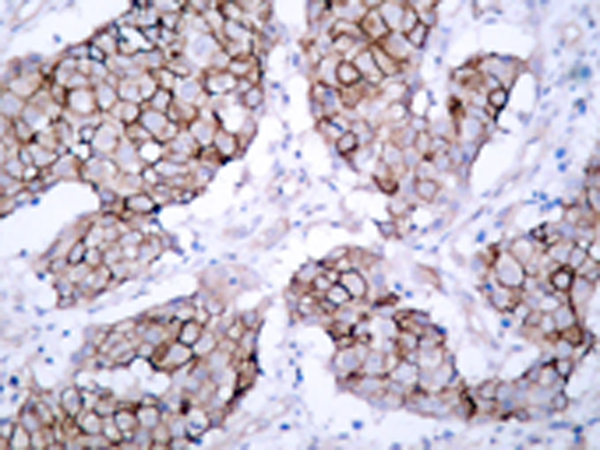

|
Background: |
Receptor for EGF, but also for other members of the EGF family, as TGF-alpha, amphiregulin, betacellulin, heparin-binding EGF-like growth factor, GP30 and vaccinia virus growth factor. Is involved in the control of cell growth and differentiation. Phosphorylates MUC1 in breast cancer cells and increases the interaction of MUC1 with SRC and CTNNB1/beta-catenin. |
|
Applications: |
WB, IHC |
|
Name of antibody: |
EGFR (Phospho-Tyr1092) |
|
Immunogen: |
Synthetic peptide of human EGFR (Phospho-Tyr1092) |
|
Full name: |
epidermal growth factor receptor (Phospho-Tyr1092) |
|
Synonyms: |
ERBB; HER1; mENA; ERBB1; PIG61 |
|
SwissProt: |
P00533 |
|
IHC positive control: |
Human breast carcinoma |
|
IHC Recommend dilution: |
50-100 |
|
WB Recommended dilution: |
500-1000 |
|
WB Positive control: |
A431 cells untreated or treated with EGF |
|
WB Predicted band size: |
175 kDa |
購(gòu)物車(chē)
幫助
021-54845833/15800441009
